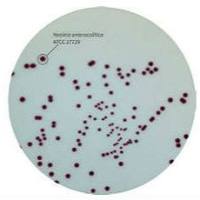
印度HiMedia耶尔森菌显色培养基

万千商家帮你免费找货
0 人在求购买到急需产品
- 详细信息
- 技术资料
- 保存条件:
常温
- 规格:
250g
产品名称:改良罗氏培养基基础
英文名称:
货号:BS1575
类别:干粉培养基>>临床培养基
规格:250g
产品说明与用途:用于结核杆菌的培养、计数、保存、照光试验、药物敏感性测定及菌型鉴定等
改良罗氏培养基基础//临床培养基 相关产品:
硝酸盐肉汤(还原)//微生物生化管
弓形虫IgM抗体测定试剂盒//诊断试剂系列
肉汤琼脂培养基/Broth Agar Medium/药品、生物制品检测培养基
硝酸盐肉汤(还原)//微生物生化管
O157显色培养基//一次性培养基平板
DMEM(低葡萄糖)//动物细胞培养基
赖氨酸脱羧酶培养基/Lysine-decarboxylase Test Broth/饲料微生物检测培养基
抗生素检定培养基5号//2010年中国药典版
氧化酶试纸//微生物生化管
氧哌嗪青霉素//抗生素产品
MUGal肉汤//显色培养基
WPM培养基 //植物细胞培养基
甘露醇卵黄多粘菌素琼脂平板(9cm)/Mannitol-Egg-Yolk-Polymyxin Agar Base/一次性培养基平板
溴酚蓝//色素系列
CCDA基础//弯曲杆菌检验培养基
4-甲基伞形酮葡糖苷酸(MUG)培养基//2010年中国药典版
水杨苷发酵管//微生物生化管
溴甲酚紫葡萄糖肉汤/Bromcresol Purple Dextrose Broth/罐头食品商业无菌检测培养基
溶血(0.1%)赫氏琼脂//临床培养基
金胺O染色液//微生物学实验配套试剂及试纸
改良罗氏培养基基础//临床培养基 相关知识:
合成培养基 合成培养基是一类化学成分和数量完全知道的培养基,它是用已知化学成分的化学药品配制而成。这类培养基化学成分精确、重复性强,但价格昂贵,而微生物又生长缓慢,所以它只适用于做一些科学研究,例如营养、代谢的研究。
改良罗氏培养基基础//临床培养基 关键词:改良罗氏培养基基础,干粉培养基,临床培养基
英文名称:
货号:BS1575
类别:干粉培养基>>临床培养基
规格:250g
产品说明与用途:用于结核杆菌的培养、计数、保存、照光试验、药物敏感性测定及菌型鉴定等
改良罗氏培养基基础//临床培养基 相关产品:
硝酸盐肉汤(还原)//微生物生化管
弓形虫IgM抗体测定试剂盒//诊断试剂系列
肉汤琼脂培养基/Broth Agar Medium/药品、生物制品检测培养基
硝酸盐肉汤(还原)//微生物生化管
O157显色培养基//一次性培养基平板
DMEM(低葡萄糖)//动物细胞培养基
赖氨酸脱羧酶培养基/Lysine-decarboxylase Test Broth/饲料微生物检测培养基
抗生素检定培养基5号//2010年中国药典版
氧化酶试纸//微生物生化管
氧哌嗪青霉素//抗生素产品
MUGal肉汤//显色培养基
WPM培养基 //植物细胞培养基
甘露醇卵黄多粘菌素琼脂平板(9cm)/Mannitol-Egg-Yolk-Polymyxin Agar Base/一次性培养基平板
溴酚蓝//色素系列
CCDA基础//弯曲杆菌检验培养基
4-甲基伞形酮葡糖苷酸(MUG)培养基//2010年中国药典版
水杨苷发酵管//微生物生化管
溴甲酚紫葡萄糖肉汤/Bromcresol Purple Dextrose Broth/罐头食品商业无菌检测培养基
溶血(0.1%)赫氏琼脂//临床培养基
金胺O染色液//微生物学实验配套试剂及试纸
改良罗氏培养基基础//临床培养基 相关知识:
合成培养基 合成培养基是一类化学成分和数量完全知道的培养基,它是用已知化学成分的化学药品配制而成。这类培养基化学成分精确、重复性强,但价格昂贵,而微生物又生长缓慢,所以它只适用于做一些科学研究,例如营养、代谢的研究。
改良罗氏培养基基础//临床培养基 关键词:改良罗氏培养基基础,干粉培养基,临床培养基
风险提示:丁香通仅作为第三方平台,为商家信息发布提供平台空间。用户咨询产品时请注意保护个人信息及财产安全,合理判断,谨慎选购商品,商家和用户对交易行为负责。对于医疗器械类产品,请先查证核实企业经营资质和医疗器械产品注册证情况。
技术资料暂无技术资料 索取技术资料
改良罗氏培养基基础
¥100 - 9999